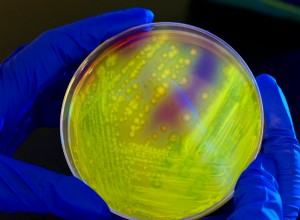
What does man have to do with the microbe? Common story! The secret life of bacteria

LUCA, the common ancestor of all living organisms on Earth, passed on to its descendants survival traits in the form of genes. Some of his offspring - presumably large - did not survive. But one group did. Bacteria appeared 3.5 billion years ago and are today the most numerous type of organism on Ea